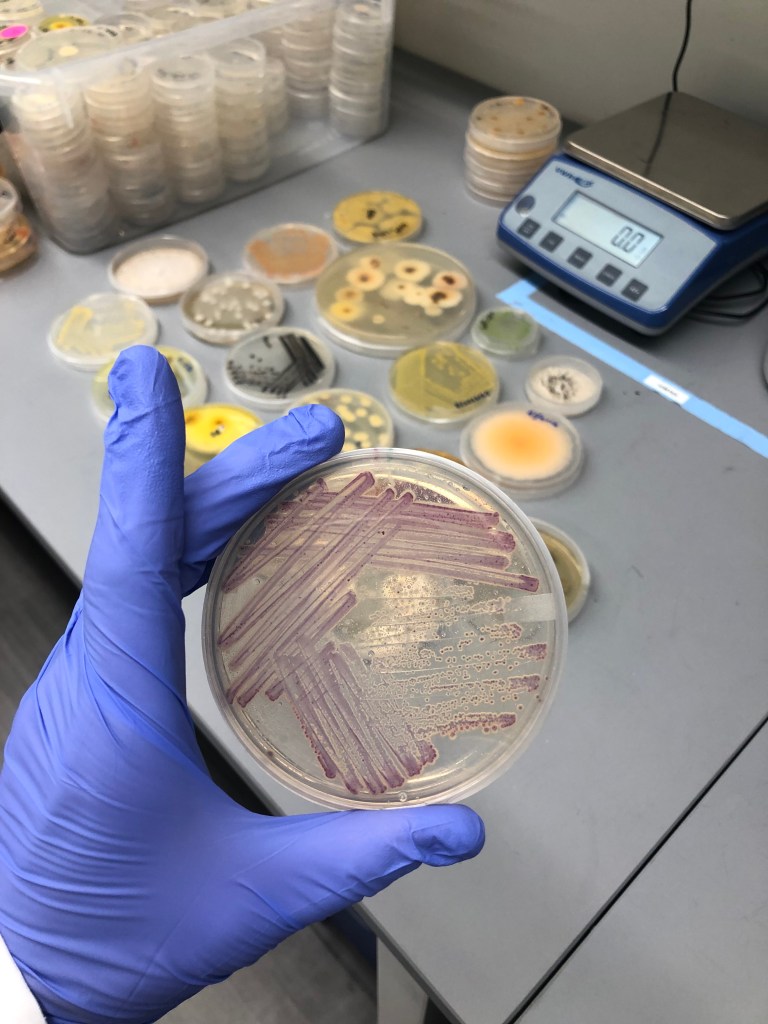

Exploring diverse microbiomes, creating microbial discovery pipelines for new applications, and developing new communication strategies for STEM
I use a systems based approach that is informed by a deep understanding of ecology and evolution to create microbial discovery pipelines that rapidly produce effective products across industries. I pair this with experience obtaining and analyzing amplicon gene sequencing datasets to better understand diverse habitats and leverage these insights for product development. I use this background to lead innovations in STEM communication.

Microbial Discovery: Insect Yeasts
My doctoral research at Tufts University and North Carolina State University revealed that paper wasps contain a jungle of bacteria, and fungi. These microbes include those involved in plant disease, those with antimicrobial activity, new species to science, and microbes that are of use to the food and beverage industry.
By using an ecologically informed approach, I created a pipeline that delivered the world’s first maltose-fermenting, lactic acid yeasts appropriate for making scalable, rapid, monoculture sour beers. These yeasts led to:
- Patent-pending brewing technology
- New insights, and peer-reviewed publications, into the evolutionary relationships between insects and yeasts (published in Proceedings of the Royal Society B)
- A spinoff startup company, Lachancea LLC, that now helps brewers in the USA and Japan make award-winning beers and ciders
- Provisional license of yeasts to a leading coffee producer for making improved coffee
- A grant to investigate the use of synthetic biology to make these yeasts appropriate for more sustainable plastic production
- 5 TED / TEDx talks and various presentations at DefCon (the world’s largest hacker conference), leading technology conferences, and commencement speeches and keynotes
- Produce a visual journalism piece for Primer Stories
- Integrate this research into an Art + Science + Augmented Reality Technology pop-up exhibit and smart phone app
Microbial Discovery: Plant Microbes
As a graduate student and postdoctoral researcher I investigated the microbes and microbial communities of insects and plants– those involved in diseases such as Sour Rot and Berry Rot in vineyards and those associated with tropical Cecropia plants. Working as an executive at Indigo Ag, the world’s largest agriculture technology start up, I helped optimize the microbial discovery and commercialization pipeline for fungal and bacterial bioinoculants to increase yields of crops such as corn, rice, wheat, and soybeans.
- Published peer reviewed publications in PeerJ and Proceedings of the Royal Society B (Cover story)
- Reduced commercial agriculture microbial product pipeline by 50% while improving pipeline quality and safety at Indigo Ag
- Lead the data science analysis of commercial data for scientific publications at Indigo Ag
- Executive contributions aided the company in securing multiple rounds of funding (>$200 million)
- Created the scientific communication strategy for a $4 billion ag technology startup (Indigo Ag), including internal strategies that resulted in novel intellectual property capture and employee training, and external communication strategies implemented on the company’s website, social media platforms, sales content

Humans & Bread Microbiomes
During my postdoctoral research fellowship at North Carolina State University I lead an investigation of the microbial communities of baker’s hands, their sourdough starters, and relationship these communities have with taste. I was also the initial project manager and lead operations of the multi-university global citizen science project on the sourdough microbial community.
- Research was highlighted by the Gastropod podcast, NPR, Scientific American, and Civil Eats
- Research was published in mSphere and presented at leading industry bread conferences
- To see the interactive online portal of our sourdough microbial ecology research results, visit this website
- Led communication efforts that resulted in interdisciplinary art + science exhibits for visually impaired communities, international conference and museum talks, and included national and international artists
As an Adjunct Assistant Professor and Technology and Research Lead in the Department of Applied Ecology at North Carolina State University I designed and coordinate the research on using environmental yeasts from insects to create improved products for the bakery industry.
- Secured innovation funding from the North Carolina Biotechnology Center
- Presented research at leading industry bread conferences
- Developed and provisionally licensed technology to a global yeast manufacturer, a national grocery chain, and a major bakery supplier

Microbes & Built Environments
During my postdoctoral research fellowship at North Carolina State University and University of Colorado, Boulder, I investigated the microbial community of nursery schools and textiles and the arthropod community of dust and primate guts.
- Created the first continental-scale atlas of arthropods in homes using marker gene amplicon sequencing techniques and a bioinformatics pipeline
- Published results in the journals Molecular Ecology and PLoS ONE
- Generated reports for a leading textile manufacturer
- Research highlighted by media outlets including Newsweek, The Washington Post, and Scientific American
- Produced published data visualizations in R using participatory citizen science data

Microbial Discovery: Antibiotics from Soil & Sediment
As a scientist at Novobiotic Pharmaceuticals, I used early versions of the iChip technology to help discovery and characterize the novel antibiotics Neocitreamicins I & II and improve the antibiotic discovery pipeline.
- Co-discoverer of the antibiotics Neocitreamicin I and II, which show anti-cancer activity
- Published findings in the Journal of Antibiotics (cover story)
- Photomicroscopy incorporated in journal cover image
- Developed company assays, SOPs, training manuals, and product development decision-making criteria

The Paper Wasp Microbiome
For the last decade and a half I have investigated the microbiome of paper wasps and their nests. I have used advanced statistical models, bioinformatics pipelines, next generation sequencing, and cultivation dependent methods to explore this world.
- Discovered and named the fungus Mucor nidicola
- Presented results at leading international and domestic academic conferences
- For more research and licensed technology that emerged from this research, please see the topics listed above